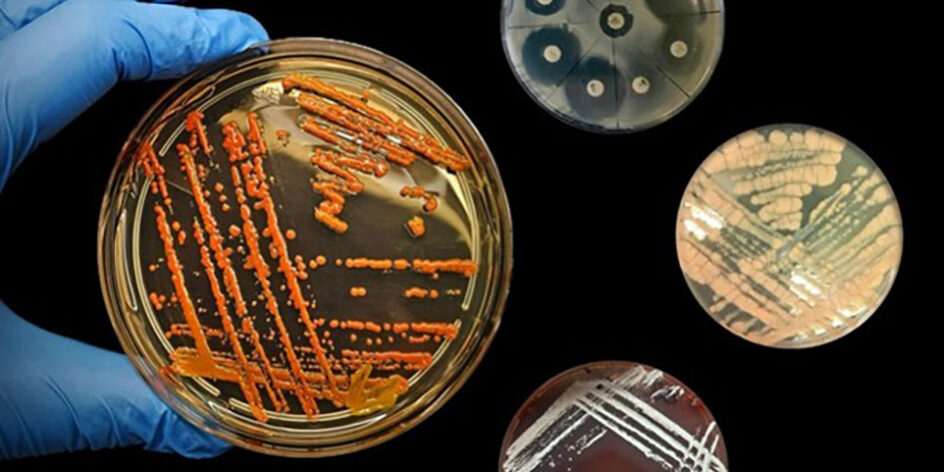
Microrganismi: alla scoperta del mondo invisibile

Microrganismi: alla scoperta del mondo invisibile
Tutto ciò che ci circonda è popolato da microrganismi: suolo, acqua, superfici, persino la nostra pelle ed il nostro corpo. Questi organismi viventi, i più antichi e numerosi del pianeta, sono invisibili ad occhio nudo a causa delle loro dimensioni microscopiche. I microrganismi svolgono ruoli ecologici vitali e producono molecole di grande interesse industriale, come gli antibiotici. Ma il loro contributo non si ferma qui: questi microrganismi sono protagonisti in numerosi altri ambiti applicativi, che spaziano dal biorisanamento all’industria alimentare.
In questa occasione, tramite l’uso dei microscopi ottici, avrai l’opportunità di osservare da vicino alcuni microrganismi come batteri e microalghe (microrganismi fotosintetici) esplorandone le differenze morfologiche, e apprezzandone la differente pigmentazione. Esploreremo inoltre come i microrganismi rispondono a vari stress (antimicrobici, agenti chimici, sali e metalli) mediante la produzione di molecole nell’ambiente esterno. Potrai conoscere microrganismi produttori di antibiotici, di particolari enzimi e potrai osservare i risultati di saggi di antibiotico-resistenza per evidenziare le risposte dei batteri all’azione degli antibiotici. Infine, con la tecnica dello spooling, potrai estrarre e vedere a occhio nudo il DNA dei microrganismi.
Un viaggio fantastico e affascinante nel mondo dei microrganismi ti aspetta!
A cura di: Rosa Alduina, Alessandro Presentato, Valeria Villanova, Fanny Claire Capri, Ylenia Di Leto, Annamaria Gallo, Enrico Tornatore, Chiara Massaro.
Questa attività è correlata alla seguente missione Horizon Europe:
- Un patto europeo per il suolo
Questa attività è correlata ai seguenti SDG (Sustainable Development Goals):
SDG 3 Garantire una vita sana
SDG 14 Conservare e utilizzare in modo durevole gli oceani, i mari e le risorse marine
SDG 15 Proteggere, ripristinare e promuovere l’uso sostenibile degli ecosistemi terrestri